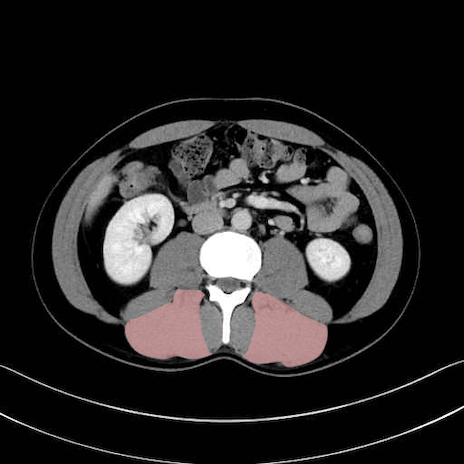

脊柱起立筋(erector spinae)のCT画像の解剖
症例
1. 体幹部(腹部・背部・後腹壁)の筋肉
腹直筋 (Rectus abdominis)
外腹斜筋 (External oblique)
内腹斜筋 (Internal oblique)
腹横筋 (Transversus abdominis)
腰方形筋 (Quadratus lumborum)
広背筋 (Latissimus dorsi)
脊柱起立筋 (Erector spinae)
多裂筋 (Multifidus)
2. 腸腰筋群と骨盤底筋
大腰筋 (Psoas major)
腸骨筋 (Iliacus)
肛門挙筋 (Levator ani)
3. 殿部の筋肉(表層・中層・深層)
大殿筋 (Gluteus maximus)
中殿筋 (Gluteus medius)
小殿筋 (Gluteus minimus)
大腿筋膜張筋 (Tensor fasciae latae)
4. 深層外旋六筋(股関節の深部)
梨状筋 (Piriformis)
内閉鎖筋 (Obturator internus)
外閉鎖筋 (Obturator externus)
大腿方形筋 (Quadratus femoris)
5. 大腿前面(大腿四頭筋群・伸筋群)
縫工筋 (Sartorius)
大腿直筋 (Rectus femoris)
外側広筋 (Vastus lateralis)
中間広筋 (Vastus intermedius)
6. 大腿内側(内転筋群)
恥骨筋 (Pectineus)
長内転筋 (Adductor longus)
短内転筋 (Adductor brevis)
大内転筋・小内転筋 (Adductor magnus / Adductor minimus)